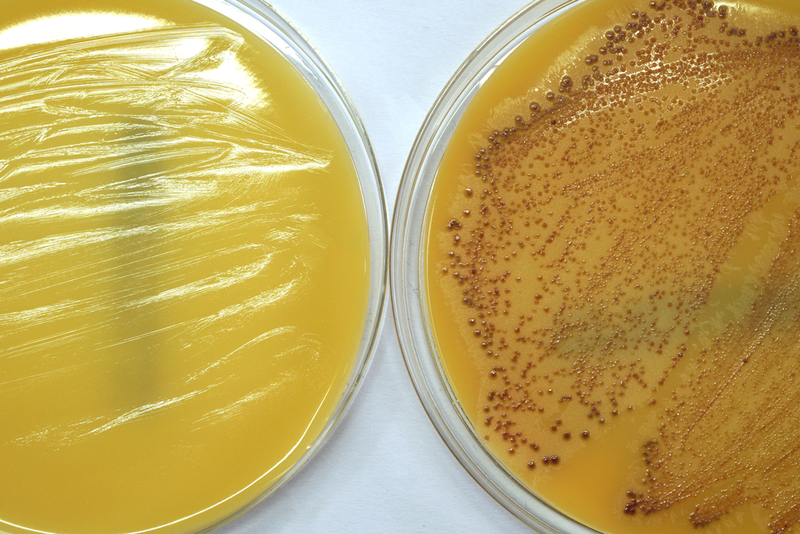

Potent antimicrobial found that shows promise in fighting staph infections
Newswise Nov 27, 2019
Research led by scientists from McMaster University has yielded a potent antimicrobial that works against the toughest infectious disease strains. The find could be the beginning of developing new therapeutics to combat drug-resistant infections.
The discovery is important as it is directly related to the development of Staphylococcus aureus diseases, known popularly as staph infections, which are the leading cause of the growing global danger of antimicrobial resistance, particularly the methicillin-resistant (MRSA) strains which are becoming resistant to all current antibiotics.
“This antimicrobial has a very exciting mode of action, kind of like hitting many birds with one stone,” said Eric Brown, senior author and a professor of biochemistry and biomedical sciences at McMaster. “This provides a promising starting point.”
After screening thousands of small molecules, the research team discovered a potent new antimicrobial they are calling MAC-545496 that is active against MRSA. Unlike conventional antibiotics, this new antimicrobial neither kills the staph infection nor halts its growth on its own, so the potential for antimicrobial resistance may be considerably lessened.
MAC-545496 cripples MRSA’s ability to cause infection by diminishing its tolerance to the hostile components of the immune system and blocking the bacterium’s capacity to resist the action of several front-line antibiotics.
To be more specific, the antimicrobial disarms MRSA from an important protein called GraR which enables the staph infection to respond to external threats, and allows the immune system to clear the infection more effectively. It also inhibits the ability of the MRSA to resist treatment by antibiotics.
First author Omar El-Halfawy, a postdoctoral fellow of biochemistry and biomedical sciences at McMaster, added: “We screened about 45,000 different compounds and found this potent bioactive, it’s the needle in the haystack. But, although it will be a long road between this discovery and clinical use, we feel we’re expanding our arsenal for combatting drug-resistant staph infections.”
The study, published today in the journal Nature Chemical Biology, was funded by the Canadian Institutes of Health Research and GlycoNet, the Canadian Glycomics Network which is one of the federally-supported networks of centres of excellence of Canada.
-
Exclusive Write-ups & Webinars by KOLs
-
Daily Quiz by specialty
-
Paid Market Research Surveys
-
Case discussions, News & Journals' summaries